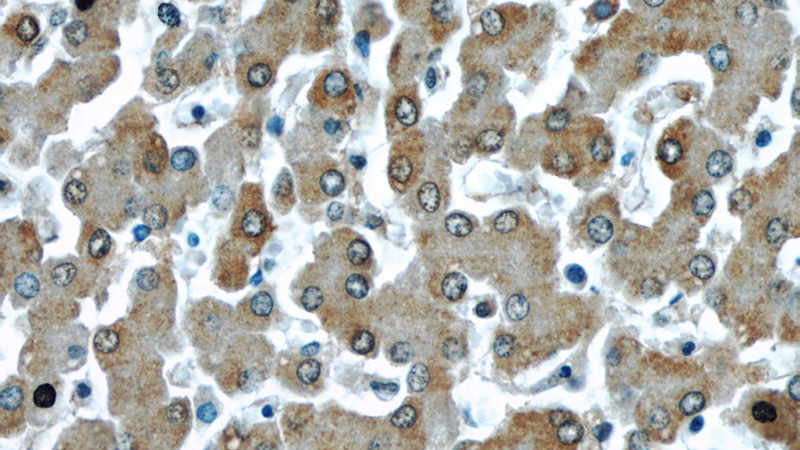
Immunohistochemical of paraffin-embedded human liver using Catalog No:111806(NOS2 antibody) at dilution of 1:50 (under 40x lens)

-
Product Name
iNOS antibody
- Documents
-
Description
iNOS Rabbit Polyclonal antibody. Positive IHC detected in human liver tissue. Positive IF detected in HeLa cells.
-
Tested applications
ELISA, IHC, IF
-
Species reactivity
Human,Mouse,Rat; other species not tested.
-
Alternative names
HEP NOS antibody; HepatOCyte NOS antibody; Inducible NO synthase antibody; Inducible NOS antibody; INOS antibody; NOS antibody; NOS type II antibody; NOS2 antibody; NOS2A antibody
-
Isotype
Rabbit IgG
-
Preparation
This antibody was obtained by immunization of Peptide (Accession Number: NM_000625). Purification method: Antigen affinity purified.
-
Clonality
Polyclonal
-
Formulation
PBS with 0.1% sodium azide and 50% glycerol pH 7.3.
-
Storage instructions
Store at -20℃. DO NOT ALIQUOT
-
Applications
Recommended Dilution:
IHC: 1:20-1:200
IF: 1:20-1:200
-
Validations

Immunohistochemical of paraffin-embedded human liver using Catalog No:111806(NOS2 antibody) at dilution of 1:50 (under 10x lens)
Immunohistochemical of paraffin-embedded human liver using Catalog No:111806(NOS2 antibody) at dilution of 1:50 (under 40x lens)

Immunofluorescent analysis of (-20oc Ethanol) fixed HeLa cells using Catalog No:111806(iNOS Antibody) at dilution of 1:50 and Alexa Fluor 488-congugated AffiniPure Goat Anti-Rabbit IgG(H+L)
-
Background
NOS2, also named as iNOS and NOS2A, produces nitric oxide (NO) which is a messenger molecule with diverse functions throughout the body. In macrophages, NO mediates tumoricidal and bactericidal actions. NO is a reactive free radical which acts as a biologic mediator in several processes, including neurotransmission and antimicrobial and antitumoral activities. NOS2 is a nitric oxide synthase which is expressed in liver and is inducible by a combination of lipopolysaccharide and certain cytokines. This antibody is specific to NOS2.
-
References
- Zhang S, Lu B, Han X. Protection of the flavonoid fraction from Rosa laevigata Michx fruit against carbon tetrachloride-induced acute liver injury in mice. Food and chemical toxicology : an international journal published for the British Industrial Biological Research Association. 55:60-9. 2013.
- Zhang S, Qi Y, Xu Y. Protective effect of flavonoid-rich extract from Rosa laevigata Michx on cerebral ischemia-reperfusion injury through suppression of apoptosis and inflammation. Neurochemistry international. 63(5):522-32. 2013.
- Xu D, Hu L, Su C. Tetrachloro-p-benzoquinone induces hepatic oxidative damage and inflammatory response, but not apoptosis in mouse: the prevention of curcumin. Toxicology and applied pharmacology. 280(2):305-13. 2014.
- Dong D, Yin L, Qi Y, Xu L, Peng J. Protective Effect of the Total Saponins from Rosa laevigata Michx Fruit against Carbon Tetrachloride-Induced Liver Fibrosis in Rats. Nutrients. 7(6):4829-50. 2015.
- Liu S, Wang ZH, Xu B, Chen K, Sun JY, Ren LP. SENP1 inhibits the IH-induced apoptosis and nitric oxide production in BV2 microglial cells. Biochemical and biophysical research communications. 467(4):651-6. 2015.
Related Products / Services
Please note: All products are "FOR RESEARCH USE ONLY AND ARE NOT INTENDED FOR DIAGNOSTIC OR THERAPEUTIC USE"
